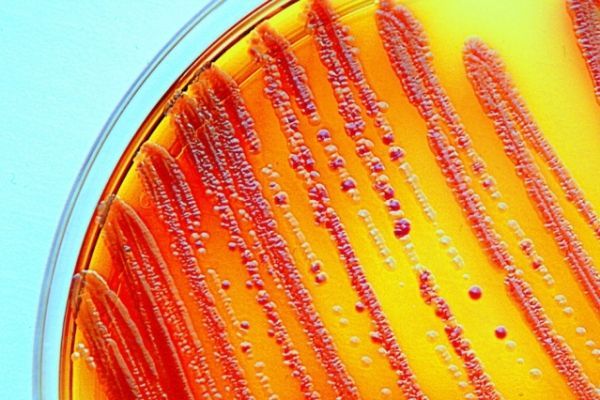

Stable ecosystems occasionally experience events that cause widespread death — for example, bacteria in the human gut may be wiped out by antibiotics, or ocean life may be depleted by overfishing. A new study from MIT physicists reveals how these events affect dynamics between different species within a community.
In their studies, performed in bacteria, the researchers found that a species with a small population size under normal conditions can increase in abundance as conditions deteriorate. These findings are consistent with a theoretical model that had been previously developed but has been difficult to test in larger organisms.
“For a single species within a complex community, an increase in mortality doesn’t necessarily mean that the net effect is that you’re going to be harmed. It could be that although the mortality itself is not good for you, the fact that your competitor species are also experiencing an increase in mortality, and they may be more sensitive to it than you are, means that you could do better,” says Jeff Gore, an MIT associate professor of physics and the senior author of the study.
Read more at Massachusetts Institute of Technology (MIT)
Image: MIT researchers have shown that in microbial communities, bacterial species with a small population size under normal conditions can increase in abundance as environmental conditions deteriorate. CREDIT: MIT